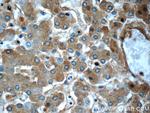
Alpha-2-macroglobulin Antibody in Immunohistochemistry (Paraffin) (IHC (P))

Search
Proteintech
Alpha-2-macroglobulin Monoclonal Antibody (4B11F7)
{{$productOrderCtrl.translations['antibody.pdp.commerceCard.promotion.promotions']}}
{{$productOrderCtrl.translations['antibody.pdp.commerceCard.promotion.viewpromo']}}
{{$productOrderCtrl.translations['antibody.pdp.commerceCard.promotion.promocode']}}: {{promo.promoCode}} {{promo.promoTitle}} {{promo.promoDescription}}. {{$productOrderCtrl.translations['antibody.pdp.commerceCard.promotion.learnmore']}}
产品信息
66126-1-IG
种属反应
宿主/亚型
分类
类型
克隆号
抗原
偶联物
形式
浓度
规格
纯化类型
保存液
内含物
保存条件
运输条件
产品详细信息
Immunogen sequence: KDNGCFRSS GSLLNNAIKG GVEDEVTLSA YITIALLEIP LTVTHPVVRN ALFCLESAWK TAQEGDHGSH VYTKALLAYA FALAGNQDKR KEVLKSLNEE AVKKDNSVHW ERPQKPKAPV GHFYEPQAPS AEVEMTSYVL LAYLTAQPAP TSEDLTSATN IVKWITKQQN AQGGFSSTQD TVVALHALSK YGAATFTRTG KAAQVTIQSS GTFSSKFQVD NNNRLLLQQV SLPELPGEYS MKVTGEGCVY LQTSLKYNIL PEKEEFPFAL GVQTLPQTCD EPKAHTSFQI SLSVSYTGSR SASNMAIVDV KMVSGFIPLK PTVKMLERSN HVSRTEVSSN HVLIYLDKVS NQTLSLFFTV LQDVPVRDLK PAIVKVYDYY ETDEFAIAEY NAPCSKDLGN A (1075-1474 aa encoded by BC040071)
靶标信息
Alpha 2-Macroglobulin (a2M), is a approximately 720-kDa homotetrameric glycoprotein composed of four identical approximately 180 kDa subunits. aAlpha 2M shares with other alpha-macroglobulins, like the complement components C3 and C4 and the pregnancy zone protein PZP, an extraordinary binding capacity for a variety of ligands. This allows the alpha-macroglobulins to serve as humoral defense barriers against foreign peptides in the plasma. Alpha 2M interacts and captures virtually any proteinase, often referred to as a panprotease inhibitor. In the brain of Alzheimer's disease (AD) patients, Alpha 2M also has been localized to diffuse amyloid plaques, supporting an important role for alpha 2M in AD etiopathology.
仅用于科研。不用于诊断过程。未经明确授权不得转售。
篇参考文献 (0)
生物信息学
蛋白别名: Alpha 2 M; Alpha-2-M; Alpha-2-M (A2M); Alpha-2-macroglobulin; alpha-2-macroglobulin precursor; C3 and PZP-like alpha-2-macroglobulin domain-containing protein 5; DKFZp779B086; S863 7
基因别名: A2M; A2MD; CPAMD5; FWP007; S863-7
UniProt ID: (Human) P01023
Entrez Gene ID: (Human) 2